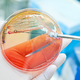

ZARADI NJE LETNO UMRE VEČ KOT 35.000 LJUDI: Sev bakterije E.coli odporen na antibiotike, primerov okužb vse več
V Evropi poročajo o naraščanju okužb s sevom bakterije E.coli, ki je odporen na karbapeneme, antibiotike, ki jih pogosto uporabljajo kot zadnjo možnost za zdravljenje resnih okužb s to bakterijo, …
Regional · 2L
e.coliodpornostrezistencabakterijaokuzbaporastevropska unijaantibiotik
V Evropi porast okužb z na antibiotike odpornim sevom bakterije E.coli

V Evropi poročajo o naraščanju okužb s sevom bakterije E.coli, ki je odporen na karbapeneme, antibiotike, ki jih pogosto uporabljajo kot zadnjo možnost za zdravljenje resnih okužb s to bakterijo, …
![]() RTV Slovenija · 2L
RTV Slovenija · 2L
V Evropi porast okužb z na antibiotike odpornim sevom bakterije E.coli

V Evropi poročajo o naraščanju okužb s sevom bakterije E.coli, ki je odporen na karbapeneme, antibiotike, ki jih pogosto uporabljajo kot zadnjo možnost za zdravljenje resnih okužb s to bakterijo, …
Dnevnik · 2L
V Evropi porast okužb z na antibiotike odpornim sevom bakterije E.coli
V Evropi poročajo o naraščanju okužb s sevom bakterije E.coli, ki je odporen na karbapeneme, antibiotike, ki jih pogosto uporabljajo kot zadnjo možnost za zdravljenje resnih okužb s to bakterijo, …
![]() 24ur · 2L
24ur · 2L
V Evropi porast okužb z na antibiotike odpornim sevom bakterije E.coli

E. coli je bakterija, ki živi v črevesju ljudi in je del normalne črevesne flore, vendar je tudi pogost povzročitelj hudih okužb. Je najpogostejši povzročitelj okužb krvnega obtoka in okužb …
![]() Večer · 2L
Večer · 2L
Z obiskom in uporabo spletnega mesta soglašate s piškotki.